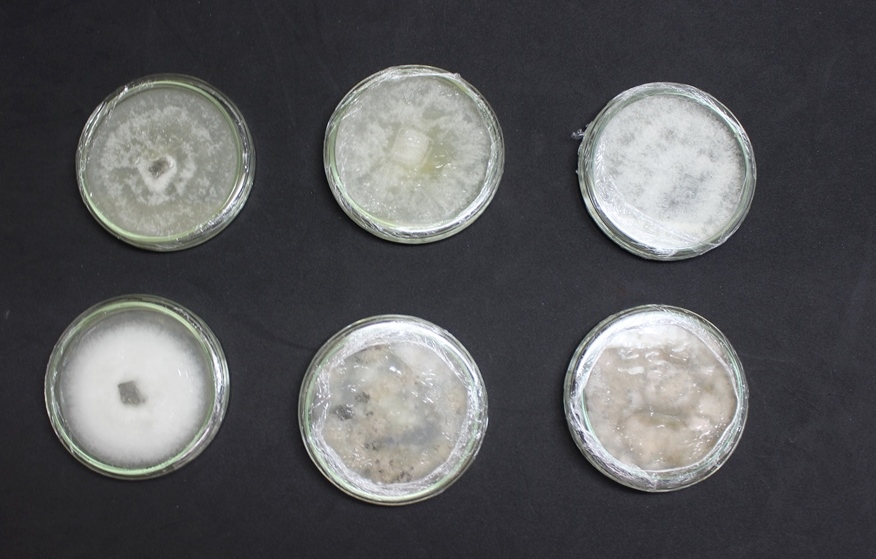

29/12/2020
Extrato produzido por fungos isolados de planta agem como inseticida natural no combate a larva do mosquito transmissor da dengue
Fonte: Gilmar Hernandes

Após pesquisas da Universidade Católica Dom Bosco (UCDB) apontarem que o óleo de uma planta do Cerrado tem potencial inseticida contra larvas do mosquito transmissor da dengue, outras pesquisas mostram ainda que fungos isolados desta planta, por meio dos seus metabólitos secundários,também tem a mesma função. De 50 fungos isolados, cerca de dez apresentaram atividade inseticida acima de 50% e dois extratos mostraram 100% de eficácia.
O pós-doc no Programa de Pós-Graduação mestrado e doutorado em Ciências Ambientais e Sustentabilidade Agropecuária da Católica, Dr. Tiago Tognolli de Almeida, orienta a pesquisa “Fungos endofíticos: substâncias secundárias com potencial inseticida, com a participação de acadêmicos de Biologia, Agronomia e Biomedicina. As pesquisas são desenvolvidas no Laboratório de entomologia do grupo de pesquisa: Uso sustentável de recursos naturais, sob coordenação da professora Dra Antônia Railda Roel.
Para a obtenção do material foram utilizadas folhas da planta Nim (Azadirachta indica), que após desinfecção superficial foi fragmentada e plaqueada em meio de cultura e colocada em uma estufa para surgirem os fungos. Após outro procedimento foi obtido extrato bruto, que aplicado nas larvas de Aedes aegypti agiu como inseticida natural em 24 horas.
“Os fungos endofíticos são microrganismos que vivem no interior das plantas e não causam prejuízo para elas, pelo contrário, podem oferecer benefícios significativos para seu hospedeiro por meio da produção de substâncias, as quais fornecem proteção e vantagens de sobrevivência para as mesmas, dentre elas, produção de enzimas, hormônios vegetais e metabólitos com ação inseticida. Desta forma a relação endófito hospedeiro pode resultar no estabelecimento de fontes alternativas de substâncias de interesse biotecnológico. Por isso que nós temos interesse nesses microrganismos para o controle de insetos ”, explica o pesquisador.
Além do combate às larvas do mosquito, o produto também é pesquisado para combater pragas nas lavouras. “O meu objetivo é o isolamento de fungos endofíticos para a aplicações biotecnológicas, principalmente para o controle pragas na agricultura”, destacou o acadêmico de Biologia, Guilherme Azevedo, integrante do Programa de Iniciação Científica (Pibic).
Nesta pesquisa foram obtidos cinco compostos químicos diferentes no extrato bruto, restando agora, segundo Almeida, a identificação de três deles, pois dois já estão identificados.